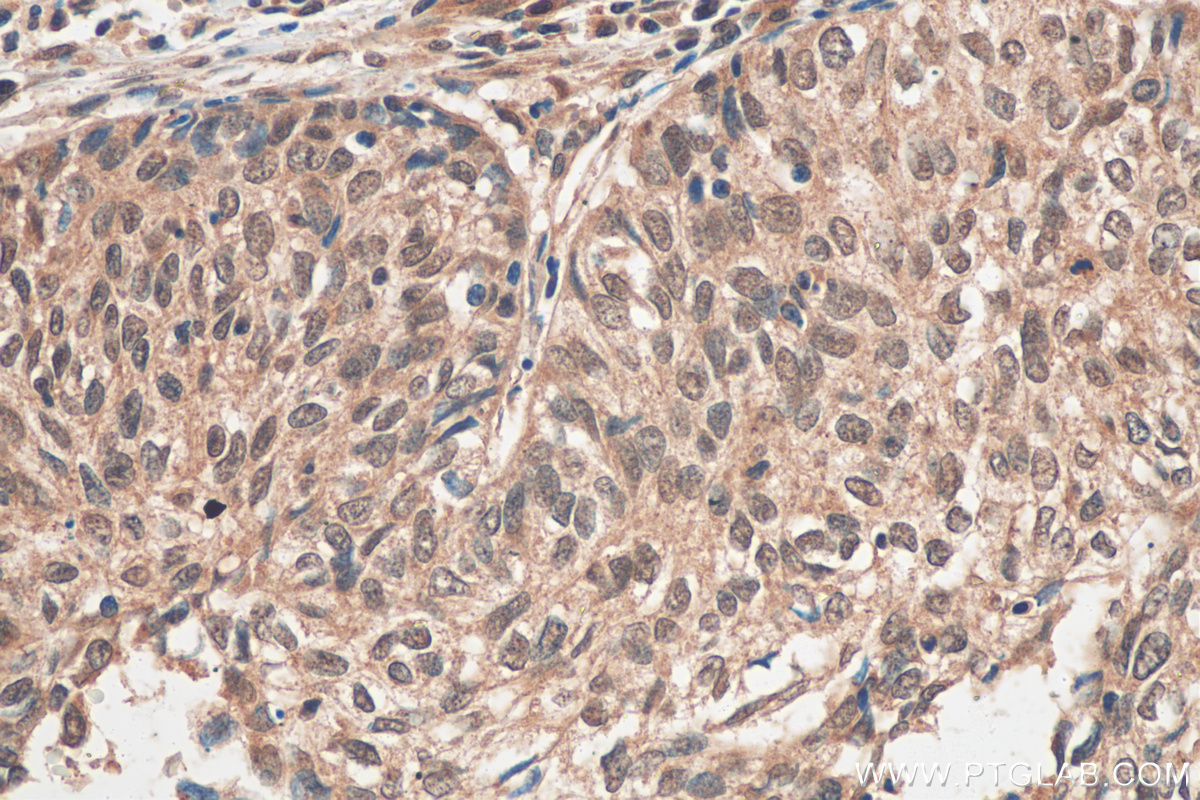

验证数据展示
经过测试的应用
| Positive WB detected in | A549 cells, Calu-1 cells, MCF-7 cells, NIH/3T3 cells, Neuro-2a cells, PC-3 cells |
| Positive IHC detected in | human placenta tissue Note: suggested antigen retrieval with TE buffer pH 9.0; (*) Alternatively, antigen retrieval may be performed with citrate buffer pH 6.0 |
| Positive IF-P detected in | mouse brain tissue |
| Positive IF/ICC detected in | MCF-7 cells |
| Positive FC (Intra) detected in | MCF-7 cells |
推荐稀释比
| 应用 | 推荐稀释比 |
|---|---|
| Western Blot (WB) | WB : 1:1000-1:8000 |
| Immunohistochemistry (IHC) | IHC : 1:50-1:500 |
| Immunofluorescence (IF)-P | IF-P : 1:50-1:500 |
| Immunofluorescence (IF)/ICC | IF/ICC : 1:200-1:800 |
| Flow Cytometry (FC) (INTRA) | FC (INTRA) : 0.40 ug per 10^6 cells in a 100 µl suspension |
| It is recommended that this reagent should be titrated in each testing system to obtain optimal results. | |
| Sample-dependent, Check data in validation data gallery. | |
产品信息
55117-1-AP targets EGR1 in WB, IHC, IF/ICC, IF-P, FC (Intra), ELISA applications and shows reactivity with human, mouse samples.
| 经测试应用 | WB, IHC, IF/ICC, IF-P, FC (Intra), ELISA Application Description |
| 文献引用应用 | WB, IHC, IF |
| 经测试反应性 | human, mouse |
| 文献引用反应性 | human, mouse |
| 免疫原 |
Peptide 种属同源性预测 |
| 宿主/亚型 | Rabbit / IgG |
| 抗体类别 | Polyclonal |
| 产品类型 | Antibody |
| 全称 | early growth response 1 |
| 别名 | AT225, early growth response 1, Early growth response protein 1, EGR 1, EGR-1 |
| 计算分子量 | 58 kDa |
| 观测分子量 | 70-80 kDa |
| GenBank蛋白编号 | NM_001964 |
| 基因名称 | EGR1 |
| Gene ID (NCBI) | 1958 |
| RRID | AB_2881272 |
| 偶联类型 | Unconjugated |
| 形式 | Liquid |
| 纯化方式 | Antigen affinity purification |
| UNIPROT ID | P18146 |
| 储存缓冲液 | PBS with 0.02% sodium azide and 50% glycerol, pH 7.3. |
| 储存条件 | Store at -20°C. Stable for one year after shipment. Aliquoting is unnecessary for -20oC storage. |
背景介绍
Early growth response 1 (EGR1) is a member of EGR family which are transcriptional factors that contain three repetitive zinc finger DNA binding domains which bind to EGR response elements (ER) to regulate target gene expression. The expression of EGR family members is induced by growth factors, with EGR1 expression being induced by NGF. Increased EGR1 expression activates transcription of other signaling molecules, including CDK5 and tyrosine hydroxylase, and exerts long term effects on neural cell growth and differentiation. Egr-1 binds to the DNA sequence 5'-CGCCCCCGC-3' (Egr-site), thereby activating transcription of target genes whose products are required for mitogenesis and differentiation. Western blotting of nuclear and cytoplasmic fractions of CNS tissue verified the cytoplasmic Egr1 as 110-kDa dimer or after denaturation as a 57-kDa version, which is reflecting its theoretical molecular weight of 57 kDa. In the nucleus Egr1 is found as 75-kDa homo- or heterodimer and as 35-kDa variant under strong denaturation.
实验方案
| Product Specific Protocols | |
|---|---|
| FC protocol for EGR1 antibody 55117-1-AP | Download protocol |
| IF protocol for EGR1 antibody 55117-1-AP | Download protocol |
| IHC protocol for EGR1 antibody 55117-1-AP | Download protocol |
| WB protocol for EGR1 antibody 55117-1-AP | Download protocol |
| Standard Protocols | |
|---|---|
| Click here to view our Standard Protocols |
发表文章
| Species | Application | Title |
|---|---|---|
Neuron Astrocytic ApoE reprograms neuronal cholesterol metabolism and histone-acetylation-mediated memory. | ||
Nat Commun Single-cell analysis of murine fibroblasts identifies neonatal to adult switching that regulates cardiomyocyte maturation. | ||
Oncogene N6-methyladenosine reader YTHDF2 promotes multiple myeloma cell proliferation through EGR1/p21cip1/waf1/CDK2-Cyclin E1 axis-mediated cell cycle transition | ||
Acta Neuropathol Commun Single-cell transcriptome sequencing reveals new epithelial-stromal associated mesenchymal-like subsets in recurrent gliomas | ||
Int Immunopharmacol DDIT3 aggravates pulpitis by modulating M1 polarization through EGR1 in macrophages |